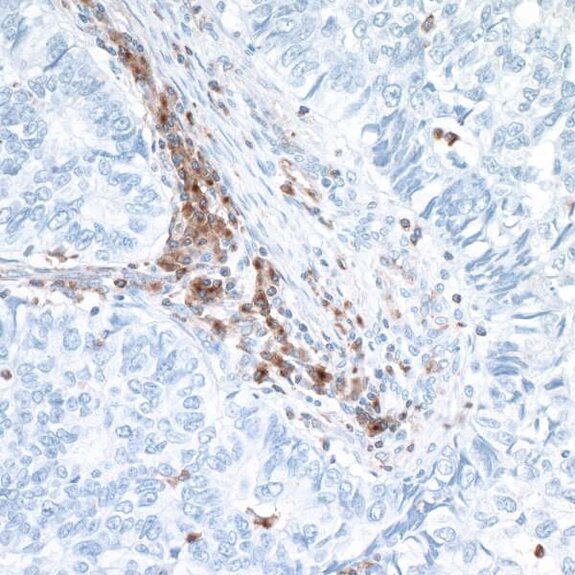
Immunohistochemistry showing brown-stained immune cell infiltration within light blue tumor tissue background

The VISTA of Cancer Treatment
In a healthy host, negative checkpoint regulators (NCRs) reign in the T cell immune response, maintaining tolerance and preventing immunopathology. However, in the tumor microenvironment, NCRs can promote immune escape. Recent clinical trials have investigated the use of blocking antibodies to prevent this NCR-driven immune escape. Targeting the NCRs cytotoxic T lymphocyte-associated molecule-4 (CTLA-4) or programmed cell death 1 (PD-1) has shown clinical promise, but either results in only a 10-20% response rate when provided as monotherapy.1 However, clinical trials with combined anti-CTLA-4 and anti-PD-1 monoclonal antibody treatment have improved response rate to 40-60%.1
The Food and Drug Administration (FDA) has approved combination treatment with monoclonal antibodies against CTLA-4 and PD-1 for multiple types of cancer.2 The rationale behind this combination therapy lies in differential regulatory mechanisms, and different target gene expression, among the various NCRs. Given the success of this combination treatment in comparison to monotherapy, there is interest in developing additional combination therapies in which multiple non-redundant NCR pathways are targeted to augment host anti-tumor immunity.
One NCR under investigation is V domain immunoglobulin suppressor of T cell activation (VISTA). Also known as platelet receptor Gi24 as well as stress-induced secreted protein-1 (SISP1),3 VISTA is a member of the B7 family of proteins. It is highly conserved among species, demonstrating approximately 80% sequence identity between humans and mice.3 VISTA is expressed primarily in lymphoid tissues, including the bone marrow, thymus, and spleen of adult mice,3 but is also expressed in other organs such as the heart, lung, brain, kidney, and muscle.4 Similar to mice, in humans, VISTA is expressed primarily in hematopoietic cell lineages and tissues containing infiltrating leukocytes.5 Unlike CTLA-4 and PD-1, VISTA is expressed on the cell surface of naïve T cells,6 meaning VISTA may function to restrict T cell immunity at phases distinct from other NCRs.6 This unique feature of VISTA may make it an attractive component of combination therapy.
In murine models, VISTA is upregulated in the tumor microenvironment and is critical in forming anti-tumor immunity.6 Interestingly, and in contrast to PD-1, VISTA is not detected in tumor cells but rather is upregulated in tumor-infiltrating leukocytes, particularly myeloid cells and Tregs.6 In human cancer, increased VISTA expression in the tumor microenvironment is significantly associated with reduced survival.7
The fact that VISTA expression is upregulated in the tumor microenvironment makes it a promising target for cancer immunotherapy. In murine solid tumor models, anti-VISTA monotherapy reduced tumor growth by enhancing T cell effector function and reducing tumor-induced differentiation of Treg.6,8 Clinical trials of monoclonal anti-VISTA for cancer treatment are in the early stages and results are not yet available.9,10 However, the hope is that once efficacy as a monotherapy is established, anti-VISTA can be incorporated into strategic combination therapy targeting multiple NCR pathways, resulting in enhanced treatment response.
Bethyl offers VISTA antibodies

References
- Postow MA, Chesney J, Pavlick AC, et al. 2015. Nivolumab and ipilimumab versus ipilimumab in untreated melanoma. N Engl J Med. May;372(21):2006-2017.
- Chae YK, Arya A, Iams W, et al. 2018. Current landscape and future of dual anti-CTLA4 and PD-1/PD-L1 blockade immunotherapy in cancer; lessons learned from clinical trials with melanoma and non-small cell lunh cancer (NSCLC). J Immunother Cancer. May;6(1):39.
- Wang L, Rubinstein R, Lines JL, et al. 2011. VISTA, a novel mouse lg superfamily ligand that negatively regulates T cell responses. J Exp Med. Mar;208(3):577-592.
- Xu W, Hieu T, Malarkannan S, et al. 2018. The structure, expression, and multifaceted role of immune-checkpoint protein VISTA as a critical regulator of anti-tumor immunity, autoimmunity, and inflammation. Cell Mol Immunol. Jan;E-pub ahead of print.
- Lines JL, Pantazi E, Mak J, et al. 2014. VISTA is an immune checkpoint molecule for human T cells. Cancer Res. Apr;74(7):1924-1932.
- Deng J, Le Mercier I, Kuta A, et al. 2016. A new VISTA on combination therapy for negative checkpoint regulator blockade. J Immunother Cancer. Dec,4:86.
- Wu L, Deng WW, Huang CF, et al. 2017. Expression of VISTA correlated with immunosuppression and synergized with CD8 to predict survival in human oral squamous cell carcinoma. Cancer Immunol Immunother. Mar;66(5):627-636.
- Le Mercier I, Chen W, Lines JL, et al. 2014. VISTA regulates the development of protective antitumor immunity. Cancer Res. Apr;74(7):1933-1944.
- ClinicalTrials.gov [Internet]. Bethesda, MD: National Library of Medicine (US). Accessed 2018 July 27. Available from: NCT02671955 study record
- Clinicaltrials.gov [Internet]. Bethesda, MD: National Library of Medicine (US). Accessed 2018 July 27. Available from: ClinicalTrials.gov study record NCT02812875